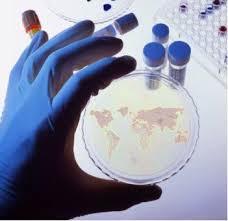

Ir al contenido principal
En la guerra sucia del terrorismo en Irak y en Siria: Irrumpen armas bacteriológicas
“Daech”, según “Le360”que cita el
diario marroquí “Al Ahdaz Al Magrebia, que a su vez cita fuentes de los
servicios alemanes, habrá propuesto tentadoras ofertas a biólogos y químicos marroquíes
afincados en Alemania para fabricar armas bacteriológicas. Los servicios marroquíes
y alemanes, según la misma fuente, están “al loro”.
Se trata de un giro muy peligroso en la estrategia del horror de la organización
terrorista llamada “Estado islámico”: en su tentativa de invertir la relación
de fuerza en su favor, frente a la intensificación de las incursiones aéreas en
las zonas que controla en Irak y en Siria, la banda terrorista estaría
actualmente enrollando a químicos y biólogos marroquíes, establecidos en Berlín,
Frankfurt y Dusseldorf, con la intención de fabricar y poseer para utilización
de armas bacteriológicas.
La noticia ha tenido el efecto de una bomba, tanto mas que la inteligencia
militar marroquí, según el citado diario, ha entrado ya en acción, en estrecha colaboración
con su homologa alemana a fin de desbaratar esta tentativa de un extremo
peligro.
Las noticias al respecto hablan de tentadoras ofertas de la cúpula del “EI”
a algunos expertos marroquíes para adquirir su servicio y preparar lo que el
mundo no habrá conocido, quizás, nunca desde la segunda guerra mundial: la utilización
de armas químicas.
En este contexto, no seria superfluo recordar que en agosto pasado un
documento sobre la utilización de armas biológicas y químicas había sido encontrado
en el ordenador de un estudiante tunecino que se había incorporado al llamado “Estado
islámico” en Siria. “El documento contenía explicaciones sobre la manera con la
que se puede recuperar el bacilo de la peste de animales infectados y
propagarlo”, recuerda Al Ahdaz al-Magrebia, que añade que en este mismo
documento, revelado por los servicios americanos, figuraban elementos de
informaciones sobre la manera con la que
este bacilo de la peste podría ser utilizado en las pequeñas granadas e incluso
en los acondicionadores de aire para causar el mayor numero de victimas
posible.
Otras revelaciones en este sentido fueron publicadas al día siguiente de la
polémica, en junio pasado, a raíz de una pretendida utilización por Daech de
armas bacteriológicas contra el ejército árabe sirio en la ciudad de Khan Al
Assal, en el nor-oeste de Alepo.
Al Ahdaz al-Magrebia recuerda también que “informaciones divulgadas últimamente,
indicaban que, además de expertos en biología y en química, Daech entró en
contacto con jóvenes magrebies especializados en informática, intendencia
civil, refinado de petróleo, cirugía y medicina de urgencia”. El rotativo marroquí
subraya al respecto que estos jóvenes se han incorporado efectivamente al
llamado “Estado islámico” en Irak y Siria, vía Turquía.
En síntesis todo apunta hacia la posibilidad de que el proyecto de la
nebulosa supera, de lejos las fronteras,
verdaderas o supuestas, de “su” zona de influencia.
Comentarios
Publicar un comentario